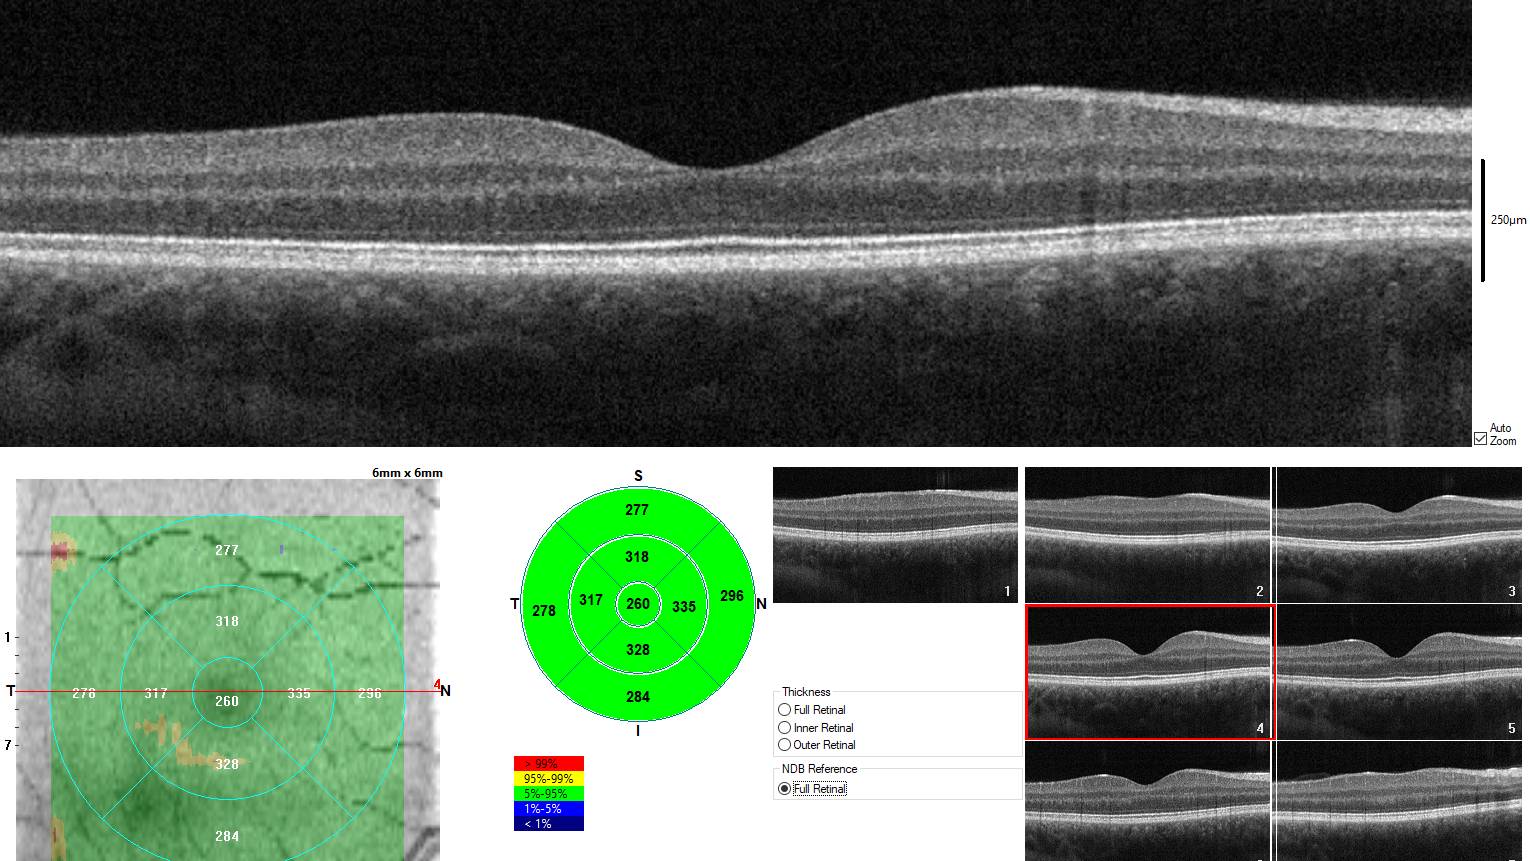
Chụp OCT giúp bác sĩ đánh giá tiến triển bệnh và hiệu quả điều trị theo thời gian

Thị giác là một trong những giác quan quan trọng nhất giúp con người kết nối với thế giới xung quanh. Mọi hình ảnh mà mắt nhìn thấy đều phải trải qua quá trình tiếp nhận xử lý và truyền tín hiệu phức tạp bên trong nhãn cầu. Trong đó, võng mạc là một bộ phận đóng vai trò trung tâm nhưng lại dễ bị bỏ qua cho đến khi xảy ra vấn đề nghiêm trọng. Việc hiểu rõ cấu trúc, chức năng cũng như các bệnh lý liên quan đến bộ phận này sẽ giúp mỗi người chủ động hơn trong việc bảo vệ đôi mắt và thị lực lâu dài.
Võng mạc là gì? Tìm hiểu về võng mạc mắt
Võng mạc là một lớp mô thần kinh mỏng nằm ở mặt trong cùng của nhãn cầu. Đây là nơi tiếp nhận ánh sáng đi vào mắt và chuyển đổi ánh sáng đó thành tín hiệu thần kinh để truyền lên não bộ thông qua dây thần kinh thị giác. Nhờ quá trình này mà con người có thể nhìn thấy hình ảnh màu sắc và chi tiết của môi trường xung quanh.
Về mặt giải phẫu, võng mạc thường có màu đỏ cam do phía sau là lớp mạch máu phong phú. Bộ phận này rất nhạy cảm và dễ bị tổn thương. Chỉ cần một rối loạn nhỏ cũng có thể ảnh hưởng trực tiếp đến thị lực, thậm chí gây mù lòa nếu không được can thiệp kịp thời.

Vị trí của võng mạc trong mắt - Võng mạc nằm ở đâu?
Võng mạc nằm ở phía trong cùng của thành nhãn cầu, phía trước là dịch kính và phía sau là lớp hắc mạc. Ánh sáng sau khi đi qua giác mạc thủy tinh thể và dịch kính sẽ hội tụ tại võng mạc. Tại đây, ánh sáng được các tế bào cảm thụ tiếp nhận và chuyển thành tín hiệu điện.
Tìm hiểu cấu tạo và chức năng của võng mạc
Võng mạc có cấu trúc phức tạp với nhiều lớp tế bào, đảm nhiệm các chức năng khác nhau. Sự phối hợp chặt chẽ giữa các lớp này giúp quá trình nhìn diễn ra chính xác và liên tục.
Cấu tạo võng mạc
Về mặt mô học, võng mạc được cấu tạo bởi 10 lớp tế bào xếp chồng lên nhau từ trong ra ngoài.
- Màng giới hạn trong: Tạo ranh giới giữa võng mạc và dịch kính.
- Lớp sợi thần kinh võng mạc: Chứa các sợi trục của tế bào hạch tập hợp thành dây thần kinh thị giác.
- Lớp tế bào hạch: Bao gồm thân tế bào hạch chịu trách nhiệm truyền tín hiệu thị giác lên não.
- Lớp rối trong: Là nơi kết nối giữa tế bào lưỡng cực và tế bào hạch.
- Lớp nhân trong: Chứa các tế bào lưỡng cực tế bào ngang và tế bào amacrine giúp điều hòa tín hiệu.
- Lớp rối ngoài: Nơi tiếp nhận tín hiệu từ các tế bào cảm quang.
- Lớp hạt ngoài: Chứa thân tế bào hình que và hình nón.
- Màng giới hạn ngoài: Phân cách các tế bào cảm quang với lớp bên ngoài.
- Lớp tế bào quang cảm thụ: Bao gồm phần ngoài và phần trong của tế bào hình que và hình nón.
- Biểu mô sắc tố võng mạc: Lớp ngoài cùng có vai trò nuôi dưỡng tế bào cảm quang và hấp thu ánh sáng dư thừa.

Chức năng của võng mạc
Chức năng chính của võng mạc là tiếp nhận ánh sáng và chuyển đổi thành tín hiệu thần kinh. Các tín hiệu này được truyền qua dây thần kinh thị giác đến trung tâm thị giác của não bộ để phân tích và tạo thành hình ảnh hoàn chỉnh.
Trong võng mạc có hai loại tế bào cảm quang quan trọng:
- Tế bào hình que: Nhạy cảm với ánh sáng yếu giúp nhìn trong điều kiện thiếu sáng và đảm nhiệm thị lực ngoại vi.
- Tế bào hình nón: Tập trung chủ yếu ở hoàng điểm giúp nhận biết màu sắc và nhìn chi tiết.
Hoàng điểm là vùng trung tâm của võng mạc - nơi tập trung mật độ tế bào hình nón cao nhất. Đây là vùng quyết định thị lực trung tâm và khả năng nhìn tinh tế như đọc chữ, nhận diện khuôn mặt, phân biệt màu sắc.

Các bệnh lý thường gặp ở võng mạc mắt
Võng mạc là cấu trúc rất nhạy cảm và có thể bị tổn thương bởi nhiều bệnh lý bẩm sinh hoặc mắc phải. Những bệnh võng mạc thường gặp bao gồm:
- Bệnh võng mạc tiểu đường: Biến chứng của đái tháo đường kéo dài gây tổn thương mao mạch võng mạc dẫn đến xuất huyết phù hoàng điểm và nguy cơ mù lòa nếu không điều trị.
- Màng trước võng mạc: Hình thành lớp mô xơ mỏng trên bề mặt võng mạc gây co kéo và méo hình ảnh, thường gặp ở người lớn tuổi hoặc sau phẫu thuật mắt.
- Thoái hóa điểm vàng: Làm suy giảm thị lực trung tâm, gây nhìn mờ, nhìn méo và xuất hiện điểm mù - đặc biệt phổ biến ở người cao tuổi.
- Lỗ hoàng điểm: Xuất hiện lỗ khuyết tại trung tâm võng mạc liên quan đến lão hóa dịch kính hoặc chấn thương gây mờ và biến dạng hình ảnh.
- Bong võng mạc: Võng mạc tách khỏi lớp biểu mô sắc tố bên dưới thường do rách võng mạc, cận thị nặng hoặc chấn thương.
- Viêm võng mạc sắc tố: Nhóm bệnh di truyền gây thoái hóa tế bào cảm quang với biểu hiện quáng gà, giảm thị lực ngoại vi và mất thị lực trung tâm theo thời gian.
- Rách võng mạc: Xuất hiện vết rách ở lớp mô thần kinh võng mạc, có nguy cơ tiến triển thành bong võng mạc nếu không xử lý sớm.
- Các bệnh khác: Tắc tĩnh mạch trung tâm võng mạc, hắc võng mạc trung tâm thanh dịch, bệnh võng mạc ở trẻ sinh non, tăng sinh dịch kính võng mạc, hội chứng Usher và u nguyên bào võng mạc.
Các phương pháp chẩn đoán và khám tình trạng võng mạc
Nhờ sự phát triển của công nghệ y học hiện đại, việc chẩn đoán các bệnh võng mạc ngày càng chính xác và sớm hơn.
Khám mắt tổng quát
Khám tổng quát giúp bác sĩ đánh giá nguy cơ tổn thương võng mạc từ sớm - đặc biệt ở người lớn tuổi, người có bệnh nền hoặc tiền sử chấn thương mắt. Bác sĩ sẽ khai thác tiền sử bệnh đo thị lực, nhãn áp,... để phát hiện các dấu hiệu bất thường ban đầu.

Soi đáy mắt
Phương pháp cơ bản này giúp quan sát toàn bộ đáy mắt, phát hiện các tổn thương võng mạc và mạch máu. Soi đáy mắt cho phép nhận diện các thay đổi vi thể như xuất tiết vi phình mạch hoặc rách võng mạc trước khi gây suy giảm thị lực rõ rệt.
Sinh hiển vi đèn khe
Giúp đánh giá chi tiết dịch kính và vùng võng mạc phía trước với độ phóng đại cao. Kỹ thuật này rất hữu ích trong phát hiện màng trước võng mạc bong dịch kính sau và các nguyên nhân gây méo hình.
Siêu âm mắt
Được sử dụng khi môi trường trong mắt bị đục, giúp phát hiện bong rách võng mạc hoặc khối bất thường.
Điện võng mạc
Đánh giá chức năng tế bào cảm quang và hỗ trợ chẩn đoán các bệnh thoái hóa di truyền. Phương pháp này giúp phát hiện suy giảm chức năng cảm quang ngay cả khi hình thái võng mạc chưa thay đổi rõ.
Soi xuyên củng mạc
Giúp phát hiện tổn thương võng mạc chu biên và các khối u nội nhãn.
Chụp OCT
OCT cho hình ảnh cắt lớp võng mạc với độ phân giải cao, giúp theo dõi phù hoàng điểm, bong võng mạc và bệnh lý điểm vàng. OCT giúp bác sĩ đánh giá tiến triển bệnh và hiệu quả điều trị theo thời gian.
Chụp ảnh màu đáy mắt trường rộng
Ghi nhận hình ảnh toàn bộ võng mạc hỗ trợ theo dõi tiến triển bệnh lâu dài.
Chụp mạch huỳnh quang
Đánh giá hệ thống mạch máu võng mạc trong các bệnh lý như đái tháo đường tăng huyết áp tắc mạch và viêm.
Hy vọng bài viết trên đây đã giúp bạn hiểu được võng mạc là gì, vị trí của võng mạc trong mắt là ở đâu, cấu tạo và chức năng của võng mạc cùng những bệnh lý liên quan. Võng mạc giữ vai trò sống còn trong quá trình nhìn và thị giác. Các bệnh lý tại đây thường tiến triển âm thầm nhưng hậu quả lại rất nghiêm trọng. Do đó, việc khám mắt định kỳ, kiểm soát tốt bệnh nền và đi khám ngay khi có dấu hiệu bất thường là chìa khóa quan trọng giúp bảo vệ thị lực bền vững.
:format(webp)/Desktop_da87817305.png)
:format(webp)/Mobile_1_0b0c1a773a.png)
/510_c447befeed.png)
/mat_610_la_can_bao_nhieu_do_cach_hieu_dung_de_bao_ve_thi_luc_1_90a6ca061f.png)
/nguoi_bi_can_ve_gia_co_het_khong_su_that_nhieu_nguoi_hieu_sai_1_5864a5d914.png)
/trong_mat_co_hat_trang_la_gi_co_nguy_hiem_khong_va_cach_xu_ly_dung_1_1cea16e44f.png)
/benh_a_z_ngua_mat_0_85ac0d230d.jpg)